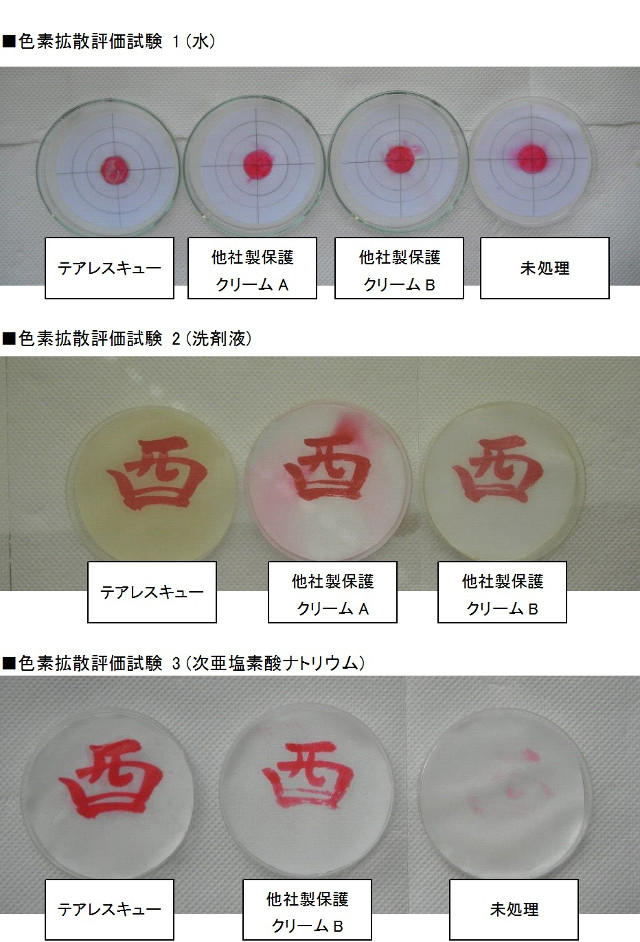

プロジェクト実行者
ストーリー

~ どうしても治らない手荒れへ ~
手袋を着けられない仕事や、日々の作業や家事で常に手肌を刺激され、ハンドクリームや手袋を着けていてさえ、手荒れに悩む皆様へ、最後の砦になりたいと思い、「テアレスキュー」を作りました。
ハンドプロテクトローション「テアレスキュー」の耐水性に優れた極薄のフィルムは、ハンドクリームとは異なり長時間、強固に手肌を保護します。

一般の方はもちろん、美容師、理容師、介護士、食品関係など、手を酷使する職業に従事するプロの方々のために開発された、従来のハンドクリームではない、手を保護する見えないフィルム製剤です。
5つの特徴
1. 目に見えない被膜(バリア層)で刺激をブロック
2. 耐水性に優れ、石鹸や洗剤でも落ちにくく長時間手肌を守る
3. クリームのようにべとつかない
4. そのまま食品に触れても安心・安全な素材を使用
5. 水分子を閉じ込め保湿効果に優れる

「テアレスキュー」 は、水分を肌に補うのではなく、皮膚の上に透明な皮膜を形成し、外から皮膚への刺激をブロック、皮膚から抜け出す水分を遮断するフィルム製剤です。保湿性の向上と外部刺激のブロックのダブルの効果により自然治癒力の促進効果を実感できます。

~ テアレスキューの使い方 ~

※使用上のご注意:手袋が不要になる製品ではございません。怪我、薬品、感染その他ご自身または他者への影響が予想される状況では必ず手袋をお使いください。
アルコールを使用しています。アレルギー体質の方でも使用できますが、必ずパッチテスト(腕の付け根の内側等で)をして下さい。アルコール過敏症の方(注射をする時にアルコール消毒した部分が赤くなる方)は必ずパッチテストをして発赤等の反応が出れば使用を控えて下さい。
もしアルコールがあかぎれや傷口に染みる場合は、先に絆創膏などで保護するか、もしくはハンドクリームをしっかりと手肌に塗り込んでいただき、その上からテアレスキューをお使いください。
~ ハンドクリームや手袋と比べると? ~
手荒れ対策としては手袋やハンドクリームが一般的です。
手袋は最も良い保護方法ですが、使用できない(職場)環境や、手袋を着けていても過剰な湿気(蒸れ)や、手袋素材とのアレルギー反応による手荒れがあります。
ハンドクリームは安価で手軽な手肌ケアですが、洗剤やお湯、もしくは摩擦など物理的なストレスに弱く、長時間保護するためには、頻繁に塗布する必要があります。
「テアレスキュー」は、従来のハンドクリームよりも耐洗剤、耐水、耐摩耗性に優れ、塗り直しの回数も少なく、長時間、強固に手肌を刺激から護ります。 そのまま食品に触れても安心・安全な素材を使用しています。
手袋を履きたくても履けない現場や、衛生面から手洗いの多い職場、手袋を履いていても手が汚れたり、荒れたりする作業環境など、様々な分野でお役に立ちます。


~ ハンドクリーム + テアレスキュー = 保湿効果が長持ちします♫ ~
テアレスキューはハンドクリームよりも強固に、長時間手肌を守る働きがありますが、ハンドクリームのような香りが無く、しっとり感よりも比較的さっぱりとした使い心地です。
お気に入りのハンドクリームをしっかりと素肌に塗り込んだのち、テアレスキューを塗るとハンドクリームの上から成膜され、クリームの欠落を抑制し、素肌への浸透を助けることができます。
テアレスキューとハンドクリームを併用することで、さらなる保湿効果とエモリエント効果が期待できます。

~ 安全。 だから安心 ~
化粧品としての申請許可を受けた成分であり、食品添加物も使用していません。医薬部外品の生産許可を受けた工場で生産しています。
初代製品は、約2年間に渡って、一般消費者及び、美容師向けに販売実績がございます。
~ テアレスキューのチカラ ~
絵の具を使用し、その上からテアレスキューと他社製保護クリームを塗布し、水、洗剤液に加えて、殺菌に使用される次亜塩素酸ナトリウムに浸漬後、絵の具の色落ちを確認しました。(色素拡散評価試験)
また、ハンドクリームを塗った後、テアレスキューと他社製保護クリームを塗布し、洗剤で洗浄後のハンドクリームの剥離、減少の度合いを重量変化で測定しました。(保護機能試験)

~ 製品仕様 ~



香川県の東端にある東かがわ市は明治時代、産業創生の一環として大阪から手袋製造の技術を持ち込み、その後、地場産業として根付きました。
弊社は地域の手袋工場の一つとして1961年に設立され、防寒手袋の生産を経て、高度成長期の日本国内と海外需要の高まりに合わせて工業用の手袋生産に転換。
1990年に中国の江蘇省に工場を設立以降、本社のある香川県高松市ではクリーンルーム用など低発塵の手袋を、中国工場では一般環境向けの工業用手袋を生産しています。
電子部品、半導体、医薬品、自動車、食品メーカー等で使用されるクリーンな手袋を製造しています。
「テアレスキュー」は、地元の研究者が約12年かけて、手肌に刺激のない、塗るだけで耐水性の見えない皮膜を形成するフィルムスキン技術を3年前に開発。美容師など手荒れに悩む職業の方に向けて塗る手袋として製品化。その後レシピを変更し、さらに使いやすい商品へと進化させました。

Q.子育て中の主婦なのですが、産まれたばかりの子供に触れても大丈夫な成分でしょうか? また、料理をしたりするときはテアレスキューを塗った手で食品に触れても大丈夫でしょうか? 手袋をしたほうがいいのでしょうか?
Answer.
テアレスキューの分類は化粧品になります。従来の化粧品と同じように食品に触るときには石鹸等で手を洗ってから触れて下さい。それによって透明な膜が破れることはありません。またテアレスキューは人体に影響がある成分を含んでいませんのでご安心下さい。
Q.テアレスキューを塗ると傷口が沁みるのですが、大丈夫ですか?
Answer.
成分であるエタノール(アルコール)が傷口に触れた際に、痛みが発生する場合があります。その場合には軟膏又はオリーブオイルを傷口に少し塗ってからテアレスキューを使用して下さい。1週間程度で痛みが消えたらテアレスキューだけを使用して下さい。但し保湿クリーム等は水分を多く含んでいるので効果的ではありません。
Q.手荒れが酷いのですが、効果があるでしょうか?
Answer.
テアレスキュー(化粧品) は薬ではありません。ただ荒れた手を新たな外部の刺激から守ります。皮膚は28日周期で新しくなりますので、自然治癒力で新しい皮膚が再生されます。
Q.途中で除けることは出来ますか?
Answer.
アルコールの含んだ濡れナプキン、ティシュ等で拭き取ることは出来ます。
Q.アトピー性皮膚炎なのですが、使用して問題はありませんか?
Answer.
テアレスキューを使用することで症状が悪化することはありません。使用する際には従来使用している薬品を塗った上からテアレスキューを塗って下さい。
Q.アレルギー体質なのですが使用は可能でしょうか?
Answer.
アレルギーにも色々な要因があります。使用する前にパッチテスト(絆創膏のガーゼ部分に塗って肌に貼って様子をみる)を行って下さい。問題が無いことを確認してからご使用下さい。アルコールに対するアレルギーがある方は、テアレスキューの成分にエタノール(アルコール)が含まれていますので特に注意をして下さい。
サポーターからの応援コメント
文章のトップに戻る
応援購入する
このプロジェクトはAll in型です。目標金額の達成に関わらず、プロジェクト終了日の2017年06月05日までに支払いを完了した時点で購入が成立します。
【18%OFF!】テアレスキュー ミニボトル50mlx1本
1,800円(税込)
(更新日:2017年06月21日)
【定価の18%OFF!先着20名様限定】
・ 一般販売価格2200円(税込)の商品を、18%引きの1800円(税込)で購入できます。
・ ハンドプロテクトローション「テアレスキュー」50ml入り を1本、お届けいたします。
・ 1回2~4プッシュ、1日2回のご使用で約2~4週間程度、お使いいただけます。
【20%OFF!】テアレスキュー ミニボトル50mlx2本
3,500円(税込)
(更新日:2017年06月21日)
【定価の20%OFF!先着20名様限定】
・ 一般販売価格4400円(税込)の商品を、20%引きの3500円(税込)で購入できます。
・ ハンドプロテクトローション「テアレスキュー」50ml入り を2本セットでお届けいたします。
・ 手荒れでお悩みのお友達や職場の仲間と一緒にお試しください。
・ 1回2~4プッシュ、1日2回のご使用で1本あたり約2~4週間程度、お使いいただけます。
【18%OFF!】テアレスキュー お徳用ボトル200mlx1本
3,600円(税込)
(更新日:2017年06月21日)
【定価の18%OFF! 先着30名様限定】
・ 一般販売価格4400円(税込)の商品を、18%引きの3600円(税込)で購入できます。
・ ハンドプロテクトローション「テアレスキュー」200ml入り を1本、お届けいたします。
・ 毎日ご自宅、職場や、ご家族でご一緒にぜひ。
・ 1回2~4プッシュ、1日2回のご使用で約2~4ヶ月程度、お使いいただけます。
【20%OFF!】テアレスキュー ミニボトル50mlx4本
7,000円(税込)
(更新日:2017年06月21日)
【定価の20%OFF!先着10名様限定】
・ 一般販売価格8800円(税込)の商品を、20%引きの7000円(税込)で購入できます。
・ ハンドプロテクトローション「テアレスキュー」50ml入り を4本セットでお届けいたします。
・ 手荒れでお悩みのお友達や職場の仲間と一緒にお試しください。
・ 1回2~4プッシュ、1日2回のご使用で1本あたり約2~4週間程度、お使いいただけます。
【早割32%OFF!】テアレスキュー ミニボトル50mlx1本
1,500円(税込)
(更新日:2017年06月21日)
【定価の32%OFF! 先着20名様限定】
・ 一般販売価格2200円(税込)の商品を、32%引きの1500円(税込)で購入できます。
・ ハンドプロテクトローション「テアレスキュー」50ml入り を1本、お届けいたします。
・ 1回2~4プッシュ、1日2回のご使用で約2~4週間程度、お使いいただけます。
【早割32%OFF!】テアレスキュー お徳用ボトル200mlx1本
3,000円(税込)
(更新日:2017年06月21日)
【定価の32%OFF! 先着20名様限定】
・ 一般販売価格4400円(税込)の商品を、32%引きの3000円(税込)で購入できます。
・ ハンドプロテクトローション「テアレスキュー」200ml入り を1本、お届けいたします。
・ 毎日ご自宅、職場や、ご家族でご一緒にぜひ。
・ 1回2~4プッシュ、1日2回のご使用で約2~4ヶ月程度、お使いいただけます。
「Makuake(マクアケ)」は、実行者の想いを応援購入によって実現するアタラシイものやサービスのプラットフォームです。このページは、 コスメ・ビューティーカテゴリの 「治らない手荒れへ!ハンドクリームではない手肌を保護する見えない皮膜テアレスキュー」プロジェクト詳細ページです。